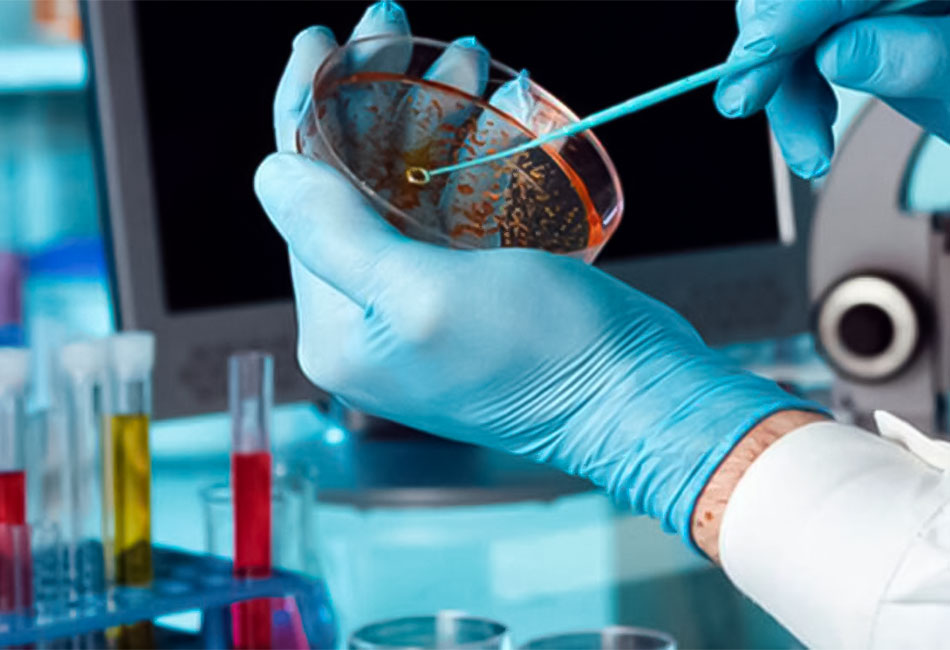

Foto: Archivo
Por: Mariana Cardosa
Como cada año en la ciencia cubana, el 2024 fue testigo de los diversos proyectos científicos y tecnológicos en los que este sector del país mostró resultados relevantes, tanto a nivel nacional como internacional, razón por la que se hace necesario recordar algunos de los principales logros del recién culminado año.
Reconocimientos a nuestros científicos
Al largo de 12 meses, Cuba fue noticia debido a diversos logros y reconocimientos otorgados a nuestros científicos, así lo vivió el país cuando Vladimir Besada y Rafael Bello, fueron seleccionados como miembros de la Academia Mundial de Ciencias, ambos formando parte de los 14 académicos escogidos en América Latina.


Besada, perteneciente al Centro de Ingeniería Genética y Biotecnología; y Bello, de la Universidad Central “Marta Abreu” de Las Villas forman parte de un total de 79 nuevos miembros que integrarán esa institución.
También se destacó el potencial humano de la ciencia en Cuba desde la revista The Lancet, con la publicación dedicada a la Dra. C Dagmar García, artículo que destaca su amplia trayectoria en el desarrollo de vacunas, entre ellas las moléculas contra la COVID-19 y la antineumocócica.

Dra. C Dagmar García Rivera / Foto: Archivo
Bajo el título Dagmar García Rivera: Una carrera de pasión y resiliencia, la publicación destaca en un perfil el quehacer de la farmacéutica, vicejefa de Investigaciones del Instituto Finlay de Vacunas, primer centro en comenzar los ensayos clínicos en humanos de dos de los cinco candidatos vacunales cubanos contra la COVID-19, en plena efervescencia de la pandemia.
Productos desarrollados en Cuba avanzan con paso firme
Con pasos firmes a nivel internacional avanzan los productos desarrollados en Cuba, entre los que resalta la vacuna Cimavax, a la que le fue otorgado el registro por el Ministerio de Salud de la República de Belarús. El reconocimiento representa un gran logro para los creadores de la primera vacuna terapéutica, patentada y registrada en el mundo contra el cáncer de pulmón.
Por su parte, el compuesto JM-20, obtenido por el Centro de Investigación y Desarrollo de Medicamentos de Cuba, logró en Nueva Zelanda la concesión del registro de una patente que reivindica su uso en la enfermedad de Parkinson.
Mientras tanto, el medicamento cubano Heberprot-P recibió la autorización para el desarrollo de un ensayo clínico en Estados Unidos, hito significativo que refleja el progreso en su programa de desarrollo clínico.
Por otra parte, sobresalió la calidad de los compuestos cubanos con la aprobación del Registro Sanitario de la vacuna Quimi-Vio que otorgó el CECMED, después de realizar un proceso riguroso de evaluación y concluir todos los ensayos clínicos requeridos, evidencias suficientes de calidad, seguridad y eficacia.
Realizan cambios significativos correspondientes a las autoridades reguladoras, adscritas a los ministerios de Salud Pública, el CITMA y el de Energía y Minas
Este año fue testigo de diversos cambios relevantes correspondientes a las autoridades reguladoras para la salud, normalización, energía y medio ambiente en Cuba. Un claro ejemplo fueron los cinco acuerdos, publicados por la Gaceta Oficial de Cuba y aprobados por el Consejo de Ministros, a solicitud del titular del Ministerio de Ciencia, Tecnología y Medio Ambiente. Los textos se refieren a la creación de autoridades nacionales reguladoras, adscritas a los ministerios de Salud Pública, el CITMA y el de Energía y Minas.
Homenajes a figuras destacadas: acto que perdura en la ciencia en Cuba

Los homenajes a las figuras MÁS destacadas de la ciencia fueron también un factor importante en el recién concluido 2024. Así se valida en la Facultad de Física de la Universidad de La Habana, donde fue inaugurada una estatua en honor a Albert Einstein, realizada por el reconocido escultor cubano José Ramón Villa Soberón, como tributo a uno de los científicos más ilustres de todos los tiempos.
Un hecho llamativo en la astronomía
La astronomía protagonizó importantes espacios durante este año con el eclipse total de Sol visible el 8 de abril, con una duración completa de dos horas y 25 minutos. El Instituto de Geofísica y Astronomía informó con antelación que sería visible en todo el archipiélago cubano. Además, convocó a la visualización pública del fenómeno desde el Observatorio Astronómico Cubano-Ruso, que radica en la propia sede de la institución.
//yma